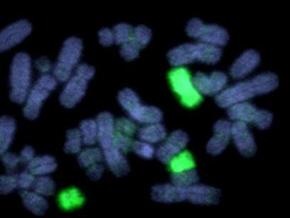
Половые хромосомы способствуют образованию новых видов

Фото: faculty.ksu.edu.sa
Хромосомы рыб рассказали ученым об эволюции
Изменения в половых хромосомах могут привести к формированию новых видов позвоночных. Такой вывод авторы сделали по результатам изучения двух видов рыб-колюшек.
Статья ученых опубликована в журнале Nature.
Традиционный взгляд на эволюцию предполагает, что новые виды образуются из-за того, что представители существующих видов вырабатывают иные, чем раньше, приспособления к условиям окружающей среды. Постепенно накопленные изменения становятся препятствием к спариванию, и тогда ученые говорят об образовании двух разных видов.
Авторы новой работы показали, что видообразование может запускаться изменениями в половых хромосомах, которые отличаются у самцов и самок. Ученые сравнивали две популяции трехиглых колюшек. Одна из них обитает в Японском море, а вторая - Тихом океане. Тихоокеанские трехиглые колюшки являются предками колюшек из Японского моря.
В геноме самцов колюшек присутствует одна Х (женская) и одна Y-хромосома (мужская). Самки содержат две Х-хромосомы. Исследователи обнаружили, что женская половая хромосома у двух видов колюшек отличается. X-хромосома колюшек из Японского моря срослась с одной из неполовых хромосом. Самцы японских рыб отличаются более агрессивным поведением при спаривании. Исследователи установили, что за агрессию "отвечает" новая половая хромосома.
Исходя из полученных данных, авторы работы предложили следующий вариант эволюции колюшек. Изменения в Х-хромосоме привели к тому, что самцы с новой хромосомой стали более агрессивными. Самки, в хромосомах которых изменений не происходило, избегали спаривания с такими самцами, и в итоге популяция колюшек из Японского моря выделилась в отдельный вид.
Между тем, в начале этого месяца группа ирландских ученых обнаружила в генетическом коде человека три гена, которые появились совсем недавно в процессе эволюции Homo sapiens.